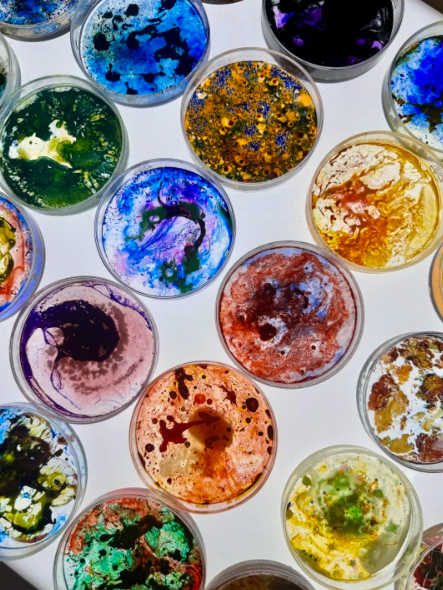

首页
新闻动态
© 2001 - 2025 BETVlCTOR伟德(BV1946-CHINA)官方网站|Ultra Platform 豫ICP备09024722号-3 豫公网安备 41012202000357号
豫公网安备 41012202000357号
 豫公网安备 41012202000357号
豫公网安备 41012202000357号
关闭
密码登录
登录
关闭
![]()
![]()
安全验证
拖动滑块解锁